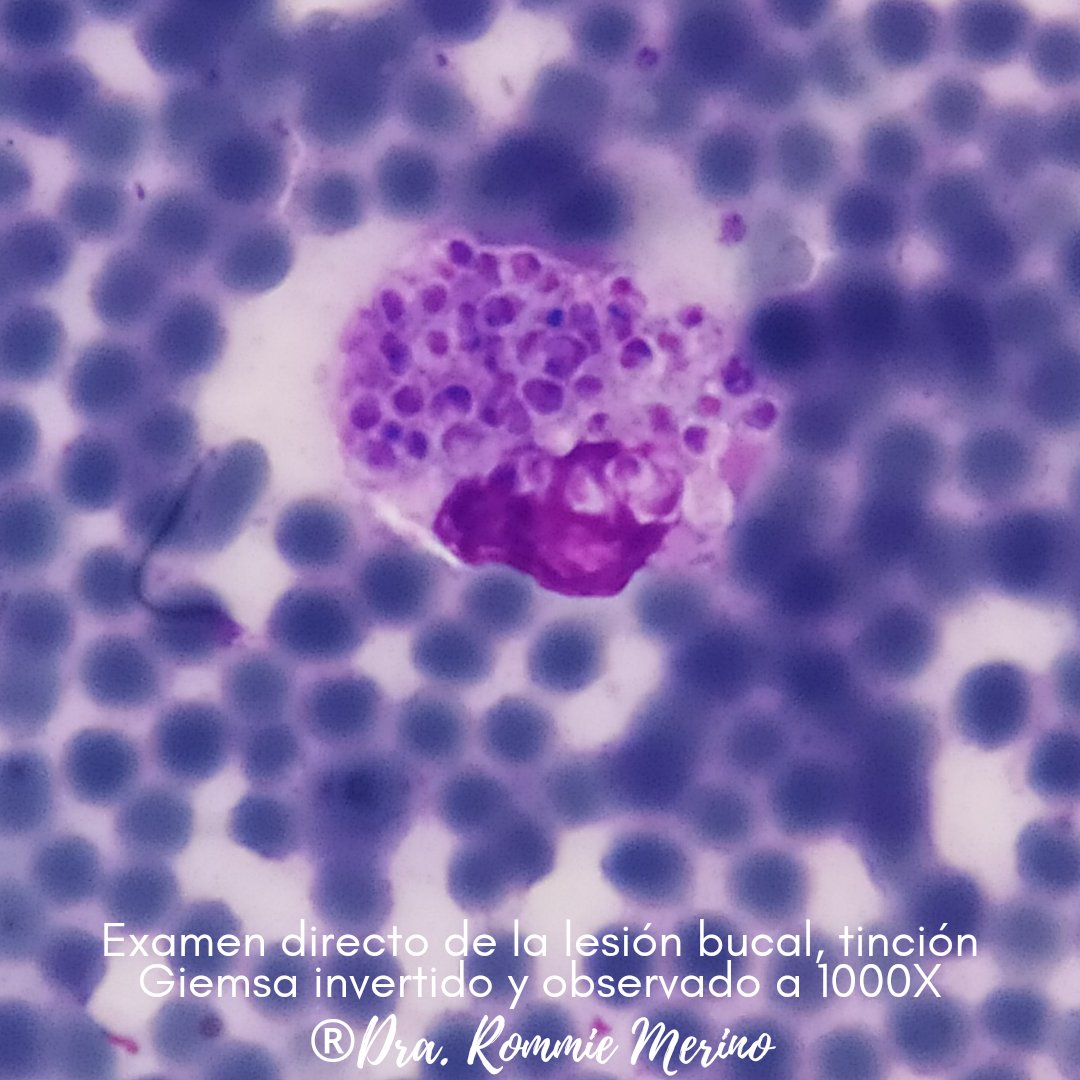
Rommiemicologia's tweet image. Disseminated histoplasmosis with oral lesions in an HIV/AIDS male patient. This case surprised me. I really expected Paracoccidioides due to particular oral manifestations (in our experience, most oral manifestations are due to PCM), but we found abundant intracellular yeast 🍄

Dustin Shackleton
@ShackletonMD
AP/CP Pathologist, Hospital Lab Medical Director | GI/Liver enthusiast | Basketball Dad 🏀 ☕️ (opinions my own; All pt data modified)
Was dir gefallen könnte
Some cancers almost seem to crawl across the slide. 🔬 #lifeofapathologist #lungcancer
This isn’t a random scientist who got lucky. Mariano Barbacid discovered the first human oncogene in 1982. He isolated H-RAS from bladder cancer cells and proved a single point mutation could trigger cancer. That finding launched the entire field of molecular oncology. KRAS…
BREAKING🚨: This is Mariano Barbacid, the scientist who may have discovered the cure for pancreatic cancer.


RIP #CatherineOHara another generational movie mom down. Can someone get a status check on Diane Wiest?
Please be safe if you decide to…mix and mingle in a jingling beat…this Holiday.
Hello everyone! Shall we demystify another molecular entity together? It may be a little dense but I hope it gets the message across! Lets start with a couple of questions 1/ #PathTwitter #IHCpath #Pathresidents #Molpath
📢CALLING ALL #MedicalLab students👩🔬🧑🔬🔬💉 (MLT, MLS, and Phlebotomy) Update social media account profiles to open to employment opportunities & grad date!🗓🧑🎓👩🎓 Start NOW to beat the rush of new grads!!!!! Employers are standing by!!!! @ASCP_Chicago @ASCLS
Smoking-Related Interstitial Fibrosis (SRIF) in Patients Presenting With Diffuse Parenchymal Lung Disease | American Journal of Clinical Pathology | Oxford Academic academic.oup.com/ajcp/advance-a…
PLEASE SHARE! 🚨 My family is asking for your help. Please email or call the Moscow Police Department tip lines in this post with any information you have that could help solve this tragic crime that has devastated our families. 📧 [email protected] 📞 (208) 883-7180

Platelets with numerous projections on its surface🧐

#PathTip #GUpath #LPpath: when screening prostate biopsies at low power &👁️ small glands traversing from one side of the core to the other ("glands crossing the street), definitely🛑stop🛑 & go down on high power!



A Bottle of water can be .50 cents at a supermarket. $2 at the gym. $3 at the movies and $6 on a plane. Same water. Only thing that changed its value was the place..So the next time you feel your worth is nothing, maybe you’re at the wrong place💯
About 90% of your early career boils down to your ability to interview. Most young people suck at it, and it shows. Want to be a millionaire? Master the art of interviewing. You'll get the job every time. Go undefeated by avoiding these 9 insanely common mistakes.
News from #ASCOPlenarySeries August session via @ASCOPost: Study Shows Germline Testing May Be Warranted for All Patients With Lung Cancer ascopost.com/news/august-20… #lcsm #germlinetesting
Another bread and butter case with fun #radpathcorrelation. Young adult with destructive sternal lesion and mediastinal lymphadenopathy. What immunostains do you want and what stage is this? #BSTpatheducation




👇This!
IF YOU SEE A YOUNG PATIENT WITH A UTERUS AND GI SYMPTOMS AND DEBILITATING PELVIC PAIN AND ALL OF HER WORKUP HAS BEEN NEGATIVE SHE HAS ENDOMETRIOSIS UNTIL PROVEN OTHERWISE
Two games tomorrow: Storm at Mystics, 12 p.m. ET, and Wings at Dream, 7:30 p.m. ET.
Submitted as uterine fibroids, largest measures 6.8 cm, up to 2 mitoses/10 HPF, no coagulative tumor cell necrosis 🎨desmin and h-Caldesmon positive #gynpath #surgpath




Disseminated histoplasmosis with oral lesions in an HIV/AIDS male patient. This case surprised me. I really expected Paracoccidioides due to particular oral manifestations (in our experience, most oral manifestations are due to PCM), but we found abundant intracellular yeast 🍄

Still waiting to see a case of gastric signet ring cell carcinoma, despite too long staring at mimics like this 🧐 B9 subnuclear vacuolization of Rubio in a gastric hyperplastic polyp. doi.org/10.1002/jso.29… #pathology



United States Trends
- 1. Anthony Kim N/A
- 2. #AEWGrandSlam N/A
- 3. Chivas N/A
- 4. #RivalsUniteInDokkan N/A
- 5. Tessa N/A
- 6. Elvis Presley N/A
- 7. Janis Joplin N/A
- 8. Gonzaga N/A
- 9. #OPLive N/A
- 10. Raven Johnson N/A
- 11. Flau’jae N/A
- 12. South Carolina N/A
- 13. #MCRMEXICO2 N/A
- 14. Marilyn Monroe N/A
- 15. Dirty Diana N/A
- 16. Wayne N/A
- 17. #GCWColdest N/A
- 18. Boardwalk Empire N/A
- 19. Rahm N/A
- 20. Vlad N/A
Something went wrong.
Something went wrong.





















































































































































